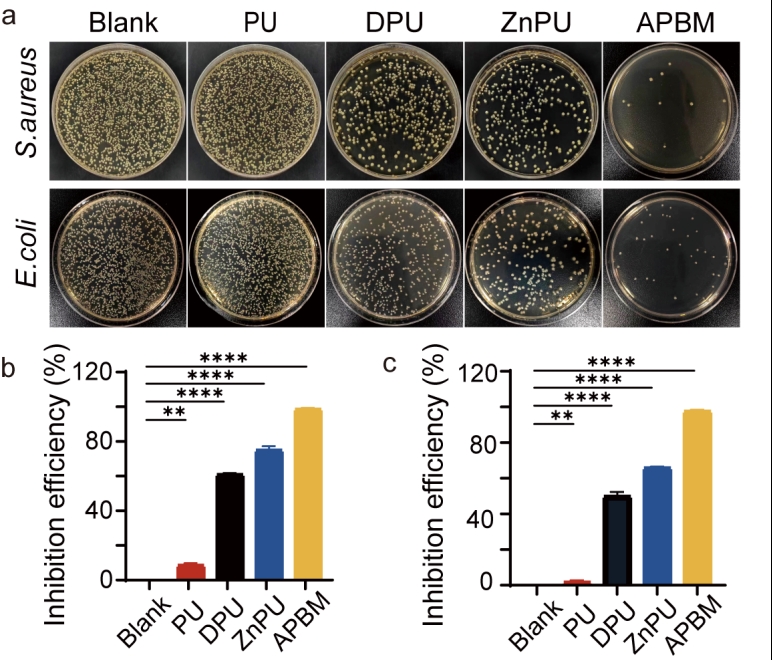

新闻网讯 针对创面感染这一全球性难题,我校肿瘤院医工创新中心邢东明教授团队首次提出“主被动协同抗菌”的防控新策略,并在新型烧烫伤创面敷料创制领域取得重要进展。近日,相关成果发表于权威期刊 Carbohydrate Polymers (中国科学院Q1,IF: 10.7,DOI: 10.1016/j.carbpol.2025.123571),该期刊为高分子材料领域全球知名期刊。硕士研究生周莎、青年教师张苗与博士研究生薛淋元为论文的共同第一作者,开运电竞,每一场竞技都是好运的开始及开运电竞,每一场竞技都是好运的开始附属医院为第一完成单位。
据世界卫生组织(WHO)统计,每年仅创面感染导致死亡的人数高达数百万,给社会及数千万家庭带来沉重负担。其中,烧烫伤创面的处置尤为棘手。因皮肤屏障缺损,烧伤创面极易成为微生物滋生的“游乐场",临床数据显示42.3%-65.8%的重度烧伤患者最终死于感染并发症。现行烧烫伤创面敷料多为物理阻隔型策略(如聚乙烯醇亲水涂层),创面感染防控能力有限。如何构建符合烧烫伤创面特点的新敷料技术,成为医患迫切之需。
邢东明教授根据烧烫伤创面感染因素多、渗液易淤积、愈合难度大的特点,创造性提出“主被动协同抗菌”与“上封下引”融合的全新策略,创新团队经过近3年的齐心努力,最终实现了高效抗菌、创面渗液调控和促愈“三位一体”功能敷料APBM的创制,为烧烫伤感染的防控带来新机遇。
如何将被动阻菌与主动抗菌有机融合,创新团队成功探索出敷料表面处理的“两步法”技术,最终实现高效主被动协同抗菌:一是“阻菌”,利用海藻酸、多巴胺自聚合在聚氨酯海绵表面构建阻隔屏障(被动阻菌),阻止细菌侵入创面。二是“抗菌”,海藻酸与锌离子高效交联,形成持续释放抗菌因子的凝胶层,遇菌即杀(主动杀菌)。同时,通过锌离子形成促愈功能。

图1. APBM制备流程及机制示意图
创新团队通过探索成功实现“短周期循环涂层”技术,通过优化的短周期、多循环交联方法,攻克了材料凝胶化改性时结构易遭破坏、孔隙率降低的制备难题,确保创面渗出液能够被高效吸收,确保了创面渗液的顺畅引流,成功实现感染创面的 “上封下引” 全新治疗模式。

图2. APBM的物理化学表征

图3. APBM的机械性能及流体管理表征
通过创新团队设计的全新细菌捕获实验证实,APBM极为高效的阻菌效能。针对大肠杆菌(E. coli)与金黄色葡萄球菌(S. aureus),其阻菌率均超过85%,能够在细菌尚未接触创面之前就发挥作用,提前有效防止细菌侵袭创面 。实验证实,金黄色葡萄球菌和大肠杆菌与APBM接触仅两小时,数量减少达99%。体现了卓越的抗菌效能。

图4. APBM与其他敷料阻菌效果的评估
图5. APBM的抗菌性能评估
在大鼠全层皮肤缺损模型中,APBM展现出显著的促愈效果:术后第15天,实验组创面愈合速度较对照组提升27.5%。组织学分析结果表明APBM胶原蛋白沉积量为对照组的3倍。炎性浸润程度少于对照组的4倍。CD31、α-SMA的表达量均为对照组的2倍。其综合性能显著优于单一抗菌策略敷料和传统聚氨酯海绵。

图6. APBM敷料可加速促进大鼠烧伤创面愈合

图7.敷料在术后第5天、第11天和第15天进行烧伤创面愈合的组织学评估
目前,我校肿瘤院医工创新团队根据自主创建的技术体系已成功构建了烧烫伤创面、钉道感染创面、引流管创面等多管线技术产品。其中,钉道感染特种敷料已完成中试产品生产,临床概念验证获得医患的高度评价,在创面感染防控、敷料便捷无痛更换、促进愈合等方面初步展现了独特优势及巨大前景。
迄今,3项国家发明专利已获受理,并获得中央引导地方科技发展基金的有力支持。